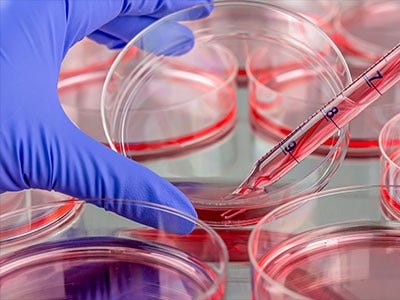
Regenerative Medicine

Life Science Research
Evident is dedicated to your work, your vision, your science. Whether you need simple brightfield or darkfield imaging, fluorescence, or elaborate 4D analysis for your research, we offer a variety of;
Upright Microscopes
Inverted microscopes
Stereo Microscopes
Laser Scanning Confocal Microscopes
We have solutions built with the proven optical and application expertise your research depends on.